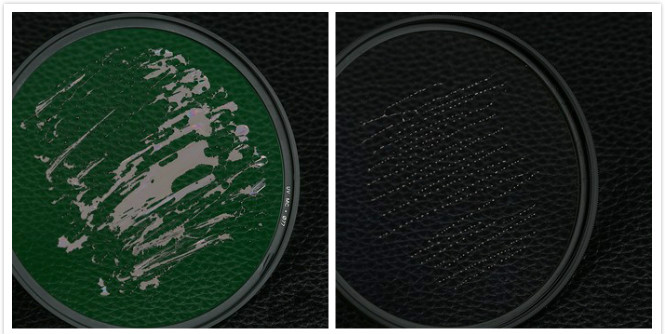

对于很多从胶片时代接触摄影的人来说,在镜头前面安装一块滤光镜是必不可少的事情,因为胶片对紫外线是感光的,所以使用胶片拍摄晴天环境的时候,经常会有不通透的感觉,而滤光镜正是可以通过滤掉阳光中的紫外线,成为胶片时代挂机滤镜的原因。而现在到了数码时代,滤光镜慢慢就变成镜头的保护镜了,这样一块小镜片不会占用太大空间、提供额外的重量,却可以有效避免镜头磕碰带来的损伤,同时也能提升镜头前镜组的防水、防尘、防污能力,使前镜组更易于清洁。
尼康“致光”系列滤光镜是尼康的高端滤镜系列,“致光”滤光镜采用高品质的光学玻璃以及高精度的研磨工艺,实现了良好的透明性和均匀性,所以这款滤光镜能够实现在拍摄时将滤镜对画质的影响降到最低。“致光”滤光镜目前共有五种规格的尺寸,分别是67mm、72mm、77mm、82mm、95mm,用户可以根据自身需求进行选择。滤光镜采用薄型框架设计,玻璃边缘有涂墨处理,可以有效地防止斜面照射的入射光形成内反射,有助于减少背光时的鬼影和眩光。

图:尼康“致光”滤光镜的五种规格
“致光”滤光镜表面采用了尼康的Zero-1防反射镀膜,实现420nm-680nm可见光区域内单面设计值接近约0.1%的低反射率,该镀膜不仅能减少鬼影和眩光的发生,还能减少安装滤光镜后造成镜头渲染力降低的情况,并且防水、防尘、防油污也少不了它的帮助。“致光”滤光镜金黄的标识辨识度非常高,相比一般滤镜的白色标识,更能突显其高端滤镜的定位,同时黑金的外观与尼康的金圈镜头放在一起也更加搭配。

图:“致光”滤光镜搭配尼康镜头效果
致光滤光镜的性能
对于滤光镜而言,多数人最关心的一定是它的性能,下面是使用尼康Z7搭配Z卡口24-70mm f/4镜头,使用72mm的“致光”滤光镜测试其对于成像的影响。

采用M挡,搭配滤镜和不搭配滤镜分别拍摄。从实拍的情况来看,能够发现无论是搭配滤镜,还是不搭配滤镜,画面的中心及边缘细节基本一致,只是在搭配滤镜时,画面的中心亮度可能稍暗,不过这种微乎其微的亮度差别,完全通过前期或后期进行调整,所以我们基本上可以说“致光”滤光镜在拍摄照片时几乎不会影响照片的画质。
致光滤光镜的抗眩光
还有就是搭配滤光镜的炫光问题,刚刚我们提到“致光”滤光镜的Zero-1防反射镀膜可以减少鬼影和眩光的发生,下面是使用尼康D800搭配24-70mm f/2.8mmG ED进行拍摄,拍摄时分别搭配77mm“致光”滤光镜和不搭配进行阳光的拍摄。

图:不搭配滤镜(上)、搭配滤镜(下)
从实拍的画面来看,能够发现无论是搭配滤镜,还是不搭配滤镜,我们看到太阳透过树叶缝隙的眩光基本一致。
防水、防油污测试
“致光”滤光镜采用了防水、防油镀膜,易于清洁。下面是一块普通的滤镜与其做对比。

图:普通的滤光镜(左)、“致光”滤光镜(右)
图:普通的滤光镜(左)、“致光”滤光镜(右)
由此可知,普通的滤镜水会滩成一片,而“致光”滤光镜的水则形成小水珠模样。另外在防油实验中,使用油性笔在两块滤光镜上滑过的感觉明显不同,普通滤光镜的表现阻尼较大,油墨连成一片,而“致光”滤光镜的表面则很滑,油墨在表面形成一个个小水珠,在后续的擦拭过程中,也会很轻松地擦掉了“致光”滤光镜镜片上的油墨,普通滤光镜的镜片则花费了很长时间功夫才擦拭差不多干净,留有少许印记。所以说,尼康“致光”滤光镜不仅相比普通滤镜更不容易被水渍油渍附着,还更易于清洁保养。
总结:简单来说,尼康的这款滤光镜有着非常不错的光学素质,几乎不会影响到拍摄的画质,同时在抗眩光方面做得又十分不错。而在保护性能方面,又可以做到防水防油污,并且做到易清洁,确实是不错的拍摄拍档。不过其售价也是一分价钱一分货,对于普通用户来说不算便宜,售价分别是67mm:820元;72mm:950元;77mm:1070元;2mm:1290元;95mm:2580元。
用户评论(共0条评论)